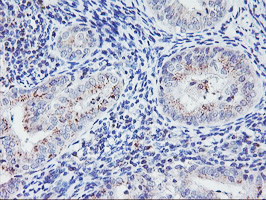
HES1 Antibody in Immunohistochemistry (Paraffin) (IHC (P))

Search
OriGene
HES1 Monoclonal Antibody (OTI7B9), TrueMAB™
{{$productOrderCtrl.translations['antibody.pdp.commerceCard.promotion.promotions']}}
{{$productOrderCtrl.translations['antibody.pdp.commerceCard.promotion.viewpromo']}}
{{$productOrderCtrl.translations['antibody.pdp.commerceCard.promotion.promocode']}}: {{promo.promoCode}} {{promo.promoTitle}} {{promo.promoDescription}}. {{$productOrderCtrl.translations['antibody.pdp.commerceCard.promotion.learnmore']}}
产品信息
TA504045
种属反应
宿主/亚型
分类
类型
克隆号
抗原
偶联物
形式
浓度
规格
纯化类型
保存液
内含物
保存条件
运输条件
靶标信息
This protein belongs to the basic helix-loop-helix family of transcription factors. It is a transcriptional repressor of genes that require a bHLH protein for their transcription. The protein has a particular type of basic domain that contains a helix interrupting protein that binds to the N-box rather than the canonical E-box.
仅用于科研。不用于诊断过程。未经明确授权不得转售。
篇参考文献 (0)
生物信息学
蛋白别名: bHLHb39; Class B basic helix-loop-helix protein 39; FLJ20408; Hairy and enhancer of split 1; Hairy homolog; Hairy-like; Hairy-like protein; HES1; hHL; RHL; Transcription factor HES-1; unnamed protein product
基因别名: BHLHB39; HES-1; HES1; HHL; HL; HRY
UniProt ID: (Human) Q14469, (Mouse) P35428, (Rat) Q04666
Entrez Gene ID: (Human) 3280, (Mouse) 15205, (Rat) 29577